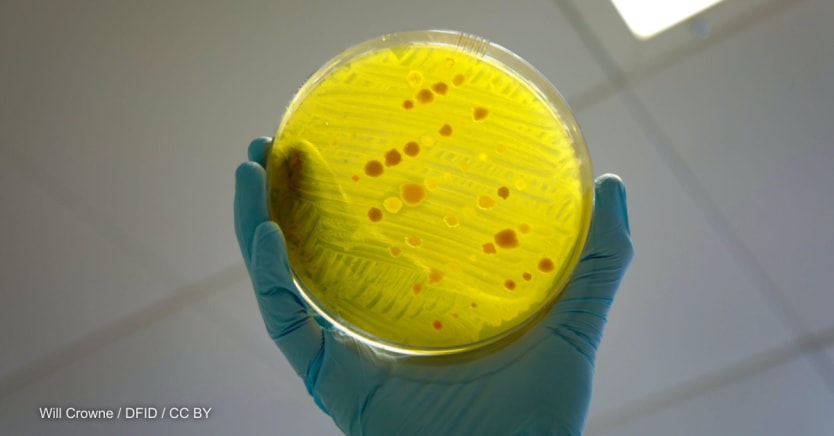

Antimicrobial resistance, or AMR, is a fast-growing health challenge that entails bacteria, viruses, fungi, and parasites no longer reacting to antibiotics and other antimicrobials. It is partly caused by misuse, overuse, or substandard use of antibiotics and has the potential to undermine critical tools in modern medicine and threaten both food security and economic development.
Left unchecked, AMR could cause 10 million deaths per year by 2050. According to the World Bank — which has more than 45 operations and about $2.6 billion of lending directed toward addressing AMR — it could push 28 million people into poverty, and wipe 3.8% off the global annual gross domestic product.
In a new report entitled Stopping the Grand Pandemic: A Framework for Action, the World Bank argues that addressing AMR must become a critical priority for governments and their development- and private-sector partners. It also highlights strategies for helping address AMR through holistic and sector-led interventions and unlocking finance to fund them. A menu of specific technical, operational, and financial considerations helps guide government action to prevent AMR.
“Antimicrobial resistance threatens global health security, human capital, and economic development,” said Mamta Murthi, vice president for human development at the World Bank. “Addressing AMR requires a comprehensive approach across agriculture, health, water and the environment. The World Bank supports countries in combating AMR through knowledge, technical assistance, and financing, and we are committed to further efforts.”
Here are five key messages from the report.
1. Addressing AMR is critical to global health security and development
AMR directly threatens progress toward many of the Sustainable Development Goals, so addressing it is vital not only for global health security but also for ensuring efforts to eradicate hunger, poverty, and inequalities are not derailed. For example, it poses a significant challenge to SDG 3 on health and well-being, as AMR makes infections harder to treat and SDG 2 on zero hunger, as difficulties treating diseases in animals can trigger a drop in food production.
SDGs can also be key to addressing AMR. For example, universal access to water, sanitation, and hygiene — a key plank of SDG 6 on clean water and sanitation — could reduce by 60% the hundreds of millions of diarrhea cases in humans each year. These cases are currently treated with antimicrobials, and thereby contribute to AMR. Achieving universal health coverage, and thereby improving access to affordable and quality health services, is also key to preventing infections — such as through vaccination or prophylaxis — and timely treatment.
Low- and middle-income countries, or LMICs, are disproportionately impacted by AMR and health care-acquired infections are highest in these countries. One reason for this is that many health care facilities in LMICs have no hand hygiene materials at the point of care.
Within these countries, vulnerable and disadvantaged people also bear a higher burden. For example, Indigenous people, and men who have sex with men are more exposed to gonorrhea — some cases of which are now almost untreatable due to antibiotic resistance. And pregnancy and childbirth, especially in settings with inadequate sanitation, expose women — who are also more likely to be excluded from education or paid work if family members require care due to drug-resistant infections — to a greater risk of contracting AMR infections.
2. Both sector-specific and multisectoral interventions are key to addressing AMR
The report points to both sector-specific and multisectoral interventions that can be effective. It flags the challenges and opportunities associated with each, provides guidance on feasibility, and introduces considerations to help maximize impact.
In doing so, the report showcases how individual countries have approached AMR with the support of the World Bank and other partners. For example, Tanzania provides an example of how improving infection prevention and control, or IPC, can yield concrete results. A joint IPC-antimicrobial stewardship program in the country helped reduce surgical site infections following cesarean sections from 48% to 17%.
China’s introduction in 2014 of regulations requiring that veterinary use of antimicrobials be accompanied by a prescription similarly demonstrates how a proposed intervention for the agriculture and food sector to increase oversight of antimicrobial use by veterinarians can work. The regulations succeeded in helping reduce antimicrobial use in animals raised for food.
For the environment and water sectors, Brazil’s experience demonstrates how improving the treatment and disposal of wastewater and sewage can help address AMR. The use of solar photo-Fenton and electro-Fenton technologies helped inactivate up to 80% of resistance-conferring genetic material added to wastewater samples from a treatment plant in the country.
3. There are four key entry points for addressing AMR
Tailored to the country’s context and needs, a range of options can be proposed, supported by political commitment and a robust enabling environment, to address AMR.
The report discusses an integrated “One Health” approach that involves mobilizing partners from multiple sectors, disciplines, and communities across four thematic areas: Reducing infections through prevention and control, vaccinations, and nutrition; strengthening monitoring and surveillance of AMR and antimicrobial use; improving access to and rational use of antimicrobials; and strengthening sectoral and multisectoral coordination and governance.
Programs aimed at addressing AMR should ideally include context-specific interventions across all four categories. However, countries’ varying levels of readiness mean such a comprehensive approach is not always feasible. In this case, having a broader vision of the range of options available and understanding their rationale can still help maximize the effectiveness, sustainability, and cost-effectiveness of individual interventions.
4. There is extensive experience to draw on in addressing AMR
The report advocates for giving early and detailed attention to implementation arrangements. Promoting awareness and ownership of the AMR agenda among influential stakeholders can help drive implementation forward, as can making decisions at the highest possible geographical level and drawing on regional mechanisms to coordinate financing and support delivery.
Examples of where these approaches have successfully supported collaboration include the East Africa Public Health Laboratory Networking Project, which was supported by the World Bank. The network of cross-country public health laboratories within East African Community member states helps monitor the transmission of communicable diseases such as tuberculosis, improves access to diagnostic services, and supports training, research, and knowledge-sharing.
Indonesia has also demonstrated how political will can be harnessed and strengthened through early collaboration with international partners. The country has taken a One Health approach to tackling AMR, strengthening its surveillance and laboratory capacity across human, animal, and environmental health. To improve its operational capacity, it has actively engaged external funders, such as the Fleming Fund and the U.S. Centers for Disease Control and Prevention, while cooperating with international organizations such as the World Health Organization.
5. Tools to cost and prioritize interventions help mobilize financing for AMR
The Framework for Action is a practical tool that countries can use to address AMR, and which World Bank teams can use to strengthen and expand their support to such countries — at the design, implementation, and evaluation stages. It builds on the World Bank’s 2021 Landscape Analysis of Tools to Address Antimicrobial Resistance, which also flagged the value of tools aimed at improving the cost and prioritization of interventions.
These tools are expected to support the mobilization of financing for AMR and help AMR be increasingly mainstreamed in projects across health, agriculture and food, water and environment, and other sectors.
The World Bank is dedicated to collaborating with countries and development partners to tackle AMR comprehensively. By leveraging knowledge, technical assistance, financing, as well as initiatives such as the Global Challenge Program for Enhanced Health Emergency Prevention, Preparedness and Response, the Bank seeks to promote a coordinated and robust approach to addressing AMR globally.
To learn more about actions that have been and can be taken to address AMR, read the full report here.







